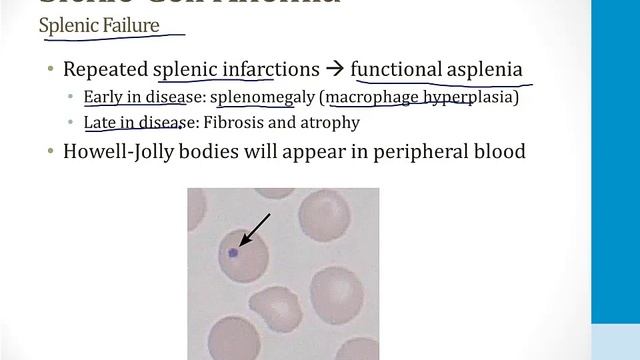
Hematology - 2. Red Blood Cells - 6.Sickle Cell Anemia atf

- Лайфстайл
- Недвижимость
- Здоровье
- Природа
- Дизайн
- Техника и оборудование
- Бизнес и предпринимательство
- Искусство
- Религия
- Строительство и ремонт
- Сад и огород
- Аудиокниги
- Кулинария
- Интервью
- Развлечения
- Лайфхаки
- Эзотерика
- Охота и рыбалка
- Наука
- Политика
- Психология
- Аудио
- Технологии и интернет
- Красота
- Телепередачи
- Детям
- Аниме
- Хобби
- Видеоигры
- Юмор
- Образование
- Спорт
- Разное
- Путешествия
- Животные
- Новости и СМИ
- Мультфильмы
- Музыка
- Сериалы
- Фильмы
- Авто-мото
Hematology - 4. Cancer Drugs - 6.Other Cancer Drugs atf
Информация
8 апреля 2025 г. 2:46:12
00:17:46
Похожие видео